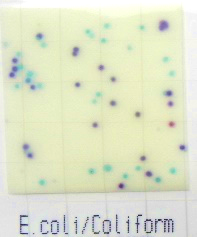

研究活動・産学官連携Research
戻る研究内容紹介
戻る
食品・栄養と健康の関係をミクロの視点で探る
- 氏名
- 向井 友花
- 所属
- 栄養学科
- 研究分野
- 栄養生化学、食品機能学、食品衛生学
| キーワード | 生活習慣病,妊娠期栄養,糖脂質代謝,腸内細菌,慢性炎症,衛生管理,微生物制御システム |
|---|
取り組み内容
食品や、食品に含まれる成分・栄養素は、ヒトの健康状態と直接的に深く関与しています。その関係性は必ずしも目に見えるものばかりではなく、ミクロの視点で見るととても複雑で興味深いものです。当研究室では、実験動物、培養細胞、微生物等を用いた分子栄養学的実験により、ミクロの視点で食品の機能性の発掘と安全性の確保を目指す基礎研究を行っています。
●食品中の生理機能性成分の代謝への作用メカニズム、および腸内環境に及ぼす影響の研究
糖尿病、肥満、動脈硬化などの生活習慣病、あるいは妊娠・授乳中の栄養バランスの偏りに起因する次世代の健康障害について、その予防や軽減の作用が期待される食品成分が、腸管内や組織・細胞内でどのような働きをしているのかを研究しています。特に、消化・吸収されずに消化管を通過して腸内細菌に影響を及ぼし、間接的に代謝や炎症の軽減に寄与するメカニズムに注目しています。
研究の対象は、日本の農産物の機能性成分(小豆・タカキビのポリフェノールやタマネギのケルセチン等)や各種アミノ酸など、幅広く扱っています。
●食品中や調理環境中の微生物制御に関する研究
食品の持つ栄養性や機能性を十分に活用するには、食品が安全・健全であることが前提となります。食品の安全性を左右する要素の一つが、食品衛生微生物です。そこで、日本国内・国外の病院給食施設の食品衛生微生物を、微生物制御の観点から調査・研究しています。
【これまでの主な卒論・修論テーマ】
- 妊娠時に摂取するフルクトースが肝細胞の脂質代謝に及ぼす影響
- タカキビ抽出物が糖尿病ラットの血中脂質および肝脂質代謝に及ぼす影響
- 妊娠期・授乳期の低たんぱく質食および授乳期の緑茶カテキンの摂取が、子の成長後の糖・脂質代謝、酸化ストレスと慢性炎症に及ぼす影響
- システインおよびロイシンの同時摂取が高脂肪食マウスの糖・脂質代謝に及ぼす影響
- ヒト大腸がん細胞を用いた曝露試験における培養条件の決定と細胞死の評価
- ベトナム社会主義共和国と日本の病院給食施設における微生物学的衛生検査